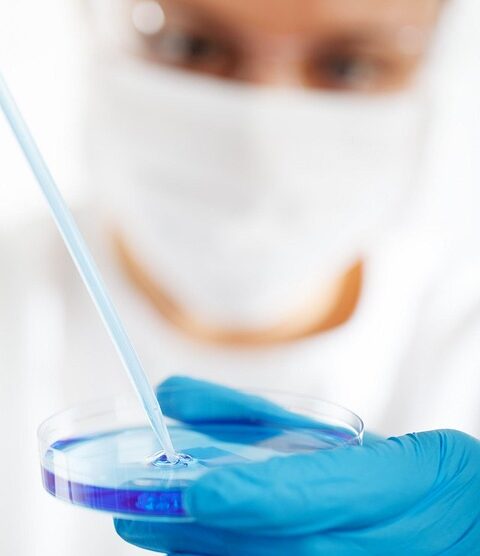

Plant Intelligence: What We’re Learning About Decision-Making in Flora Introduction For centuries, the perception of plants has been limited to mere organisms that passively absorb sunlight and nutrients. However, recent scientific advancements are challenging this notion, revealing a...
Layout A (with pagination)
What Makes Us Human? The Biological Features That Define Us Understanding what makes us human is a complex inquiry that has puzzled philosophers, scientists, and scholars across disciplines for centuries. While cultural, social, and psychological factors heavily influence our identity...
Inside the Animal Mind: Exploring Cognition Through Avian Intelligence Introduction The realm of animal cognition has long fascinated scientists and laypeople alike. Among the diverse species that populate our planet, birds have emerged as particularly compelling subjects for the study of...
From Seed to Success: How Genetic Engineering is Transforming Agriculture Agriculture has always been the backbone of human civilization, yet the challenges it faces today are unprecedented. As the global population soars, traditional farming methods are increasingly strained under the...
The Physics of Superheroes: Real Science Behind Comic Book Powers Superheroes have captivated our imaginations since their inception in comic books and films. Characters like Spider-Man, Superman, and the Hulk wield powers that we can only dream of, but what if we could analyze these...